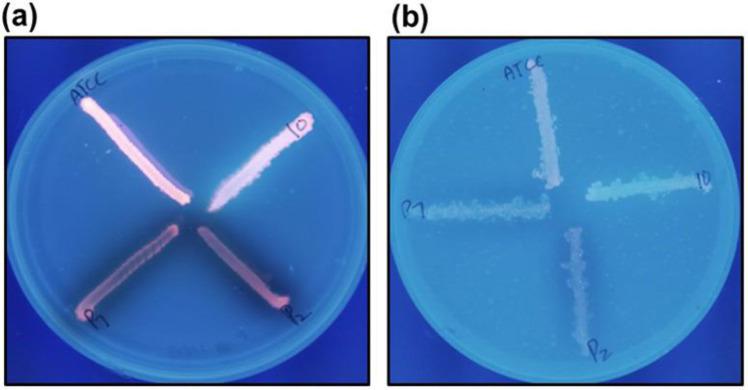
https://cdn.ncbi.nlm.nih.gov/pmc/blobs/75cd/12331453/f4da7a13746e/IJM-17-569-g004.jpg

探索新型酰胺作为外排泵抑制剂以克服多重耐药菌中的抗生素耐药性
Exploring novel amides as efflux pump inhibitors for overcoming antibiotic resistance in multidrug-resistant .
作者信息
Ullah Fahad, Ali Maqsood, Niaz Falak, Khan Israr Ali, Khan Sher Wali, Khan Momin, Ishaq Rafaqat, Manan Abdul, Yu Ying, Ilyas Muhammad
机构信息
Department of Microbiology, Institute of Pathology and Diagnostic Medicine, Khyber Medical University, Peshawar, Pakistan.
Center for Stem Cells and Regenerative Medicine, Department of Orthopedic Surgery of the Second Affiliated Hospital, Zhejiang University School of Medicine, Hangzhou, China.
出版信息
Iran J Microbiol. 2025 Aug;17(4):569-576. doi: 10.18502/ijm.v17i4.19271.
BACKGROUND AND OBJECTIVES
, a multidrug-resistant bacterium, represents a considerable risk in healthcare environments owing to its capacity to induce various infections. The resistance of is frequently linked to efflux pumps that actively remove antibiotics from the bacterial cell. This study investigates novel amide compounds as potential alternatives to address isolates exhibiting multidrug resistance mediated by efflux pumps.
MATERIALS AND METHODS
Gram staining and biochemical assays revealed thirty-three multi-drug-resistant isolates from a tertiary care hospital Peshawar. After antibiotic susceptibility testing, efflux pumps were detected using Ethidium Bromide (EtBr) agar cartwheel technique and UV transilluminator. Novel amides were tested for efflux pump and anti-pseudomonal action against efflux pump-positive isolates utilizing agar well diffusion and micro broth dilution, including synergy with ciprofloxacin and gentamicin.
RESULTS
Three high efflux pump activity isolates were chosen using ETBr agar cartwheel technique. Novel amides (ITC, ITD, ITE, DEP) block efflux pump, although TEM-cu is very antimicrobial. TEM-cu, DEP, ITC, and ITE have 0.19, 0.78, and 0.78 mg/ml MICs. Effectiveness against efflux pump-expressing is lowest with ITE (1.56 mg/ml). Together with ciprofloxacin and gentamicin, TEM-cu and DEP improved antimicrobial effectiveness.
CONCLUSION
TEM-cu is highly effective against efflux pump-positive , while amides like ITC, ITD, ITE, and DEP block these pumps. With significant reductions, DEP and TEM-cu improve ciprofloxacin and gentamicin efficacy. This method may help overcome efflux pump-mediated resistance.
背景与目的
[细菌名称]作为一种多重耐药菌,因其能够引发多种感染,在医疗环境中构成了相当大的风险。[细菌名称]的耐药性通常与主动将抗生素从细菌细胞中清除的外排泵有关。本研究调查新型酰胺化合物作为潜在替代物,以应对表现出由外排泵介导的多重耐药性的[细菌名称]分离株。
材料与方法
革兰氏染色和生化分析从白沙瓦一家三级护理医院中鉴定出33株多重耐药[细菌名称]分离株。在进行抗生素敏感性测试后,使用溴化乙锭(EtBr)琼脂车轮技术和紫外线透射仪检测外排泵。利用琼脂孔扩散法和微量肉汤稀释法测试新型酰胺对外排泵阳性分离株的外排泵抑制作用和抗假单胞菌作用,包括与环丙沙星和庆大霉素的协同作用。
结果
使用ETBr琼脂车轮技术选择了三株具有高外排泵活性的[细菌名称]分离株。新型酰胺(ITC、ITD、ITE、DEP)可阻断外排泵,尽管TEM-cu具有很强的抗菌活性。TEM-cu、DEP、ITC和ITE的最低抑菌浓度(MIC)分别为0.19、0.78和0.78毫克/毫升。ITE对表达外排泵的[细菌名称]的有效性最低(1.56毫克/毫升)。与环丙沙星和庆大霉素联合使用时,TEM-cu和DEP提高了抗菌效果。
结论
TEM-cu对外排泵阳性的[细菌名称]高度有效,而ITC、ITD、ITE和DEP等酰胺可阻断这些泵。DEP和TEM-cu可显著提高环丙沙星和庆大霉素的疗效。该方法可能有助于克服[细菌名称]外排泵介导的耐药性。